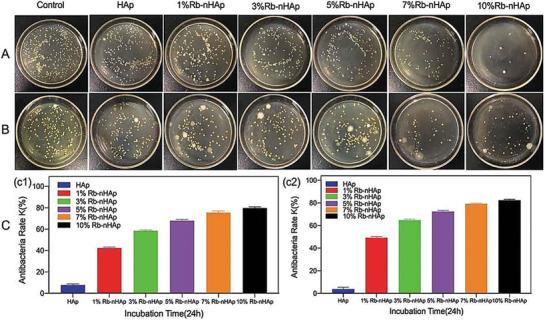
https://cdn.ncbi.nlm.nih.gov/pmc/blobs/b589/11809427/9fbe30b658e8/ADVS-12-2406324-g012.jpg

免疫调节元素周期表及衍生的二维生物材料
Periodic Table of Immunomodulatory Elements and Derived Two-Dimensional Biomaterials.
作者信息
Rafieerad Alireza, Saleth Leena Regi, Khanahmadi Soofia, Amiri Ahmad, Alagarsamy Keshav Narayan, Dhingra Sanjiv
机构信息
Institute of Cardiovascular Sciences, St. Boniface Hospital Albrechtsen Research Centre, Biomedical Engineering Program, Department of Physiology and Pathophysiology, Rady Faculty of Health Sciences, University of Manitoba, Winnipeg, Manitoba, R2H2A6, Canada.
Institute for Molecular Biosciences, Johann Wolfgang Goethe Universität, 60438, Frankfurt am Main, Germany.
出版信息
Adv Sci (Weinh). 2025 Feb;12(6):e2406324. doi: 10.1002/advs.202406324. Epub 2025 Jan 3.
Periodic table of chemical elements serves as the foundation of material chemistry, impacting human health in many different ways. It contributes to the creation, growth, and manipulation of functional metallic, ceramic, metalloid, polymeric, and carbon-based materials on and near an atomic scale. Recent nanotechnology advancements have revolutionized the field of biomedical engineering to tackle longstanding clinical challenges. The use of nano-biomaterials has gained traction in medicine, specifically in the areas of nano-immunoengineering to treat inflammatory and infectious diseases. Two-dimensional (2D) nanomaterials have been found to possess high bioactive surface area and compatibility with human and mammalian cells at controlled doses. Furthermore, these biomaterials have intrinsic immunomodulatory properties, which is crucial for their application in immuno-nanomedicine. While significant progress has been made in understanding their bioactivity and biocompatibility, the exact immunomodulatory responses and mechanisms of these materials are still being explored. Current work outlines an innovative "immunomodulatory periodic table of elements" beyond the periodic table of life, medicine, and microbial genomics and comprehensively reviews the role of each element in designing immunoengineered 2D biomaterials in a group-wise manner. It recapitulates the most recent advances in immunomodulatory nanomaterials, paving the way for the development of new mono, hybrid, composite, and hetero-structured biomaterials.
化学元素周期表是材料化学的基础,以多种不同方式影响着人类健康。它有助于在原子尺度及接近原子尺度的范围内创造、生长和操控功能性金属、陶瓷、类金属、聚合物和碳基材料。近期纳米技术的进步彻底改变了生物医学工程领域,以应对长期存在的临床挑战。纳米生物材料的应用在医学领域越来越受到关注,特别是在纳米免疫工程治疗炎症和感染性疾病方面。已发现二维(2D)纳米材料具有高生物活性表面积,并且在可控剂量下与人类和哺乳动物细胞具有相容性。此外,这些生物材料具有内在的免疫调节特性,这对它们在免疫纳米医学中的应用至关重要。虽然在理解它们的生物活性和生物相容性方面已经取得了重大进展,但这些材料的确切免疫调节反应和机制仍在探索中。当前的工作勾勒出了一个超越生命、医学和微生物基因组学周期表的创新性“免疫调节元素周期表”,并以分组的方式全面综述了每种元素在设计免疫工程二维生物材料中的作用。它总结了免疫调节纳米材料的最新进展,为新型单一、混合、复合和异质结构生物材料的开发铺平了道路。